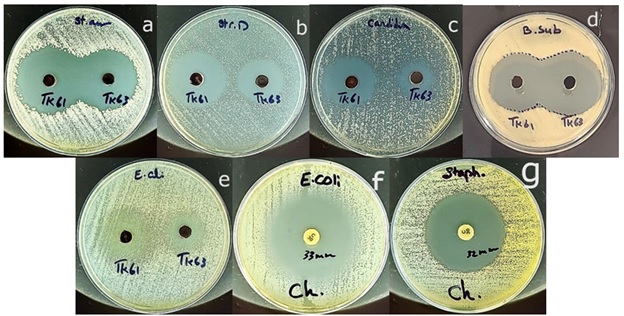

Document Type : Original Article
Authors
Chemistry Department, Payame Noor University, 19395-4697, Tehran, Iran
Abstract
A new oxovanadium (V) complex, 2-[(E)-(O-hydroxyplenyl) methylideneamino]-5-guanidinovalerat (quinoline-8-olatoN,O) vanadium oxide (V), [VO(L)(Hq)], (L=(Z)-2-(2-hydroxybenzylideneamino)-5-guanidinopentanoic acid, Hq=quinolin-8-ol), was synthesized from vanadyl acetylacetonate, 2-hydroxybenzaldehyde, L-Arginine, and quinolin-8-ol in methanol, and characterized by 1H-NMR, 13C-NMR, UV-Vis, FT-IR spectroscopy, cyclic voltammetry, and elemental analysis. Analytical data confirmed the coordination of ligand to vanadium in a 1:1 ratio, forming a stable octahedral complex. Antimicrobial activity of [VO(L)(Hq)] was compared to methoxyoxobis (quinoline-8-olato-k2N,O) vanadium(V), [VO(Hq)2(CH3O)], which has no Schiff base ligand, by testing against Gram-positive, Gram-negative bacteria, and Candida albicans fungus. The [VO(L)(Hq)] exhibited enhanced antibacterial and antifungal properties attributed to the azomethine group of the Schiff base. The Schiff base ligand coordination provides an effective approach for tuning the biological properties of metal complexes. These results highlight [VO(L)(Hq)] as a potential new antimicrobial therapeutic agent.
Graphical Abstract
Keywords
Main Subjects
Introduction
Schiff bases containing C=N-R groups were discovered by Hugo Schiff in 1864[1]. They can be used as organic ligands to donate electrons to metal ions to form stable complexes[2]. Schiff bases produced through the condensation reaction between amino acids and salicylaldehyde are extensively utilized as tridentate ONO donor ligands for synthesizing novel transition metal complexes with various bioactivities, such as DNA-binding [3], antioxidant [4], anticancer [5], antifungal [6], and antibacterial [7]. Electron delocalization in Schiff bases contributes to their stability and ability to penetrate bacterial cell membranes [8,9]. In the pharmaceutical industry, quinoline-8-ol has become one of the most important chelating agents[10], and is used to synthesize complexes with anticancer [11], antifungal [12], antibacterial [13], and anti-HIV [14] properties. The ability of vanadium complexes to exhibit various oxidation states (III-V) and form stable complexes with biological properties makes them attractive in biology and medicine[15]. Using an arginine-derived Schiff base to modulate the bioactivity of oxovanadium complexes is a new approach that provides insight into structure-function relationships. The aim was to prepare and structurally characterize an unreported vanadyl Schiff base complex incorporating 2-hydroxybenzaldehyde, L-arginine, and quinoline-8-ol as ligands, and to evaluate the impact of Schiff base coordination on antimicrobial activity. This Schiff base complex expands the knowledge of how ligand identity affects antimicrobial properties.
Materials and methods
Vanadyl acetylacetonate [VO(acac)2], ethanol, methanol, 2-hydroxybenzaldehyde, l-arginine, quinoline-8-ol, and VOSO4.3H2O were obtained from Merck and used as received. A Thermo Nicolet AVATAR 370 FT-IR spectrophotometer was used to obtain infrared spectra in the wavelength region of 400-4000 cm−1. Carbon and proton Nuclear Magnetic Resonance were obtained in DMSO-d6 using a VARIAN-INOVA 500 MHz spectrometer. A Barnsted Electrothermal 9200 apparatus used to determine the melting points. Elemental analysis was carried out on a Thermo Flash Elemental Analyzer 1112 EA. Cyclic voltammetry was performed using a Metrohm Autolab PGSTAT101 potentiostat. UV-Vis absorption spectra were recorded on a CECIL 8000 spectrophotometer using acetonitrile and DMSO solutions.
Synthesis of (Z)-2-(2-hydroxybenzylideneamino)-5-guanidinopentanoic acid, (L)
According to the literature [16], ligand (L) was synthesized by refluxing (1.56 g, 9 mmol) amino acid (L-arginine) and (1 ml, 9 mmol) 2-hydroxybenzaldehyde in 40 ml ethanol for 24 hours. The reaction was facilitated by adding drops of 0.1 M NaOH. The solid product, in bright-yellow color, was obtained in 95% yield (2.37 g) after filtering, washing three times with ethanol (5 mL), and drying at room temperature.
Synthesis of 2-[(E)-(O-hydroxyplenyl) methylideneamino]-5-guanidinovalerat (quinoline-8-olatoN, O) vanadium oxide (V)
Ligand (L) (0.55 g, 2 mmol), and VO (acac) 2 (0.53 g, 2 mmol) were dissolved in methanol (30 mL) and refluxed for 24 hours. Initially, the bluish solvent turned to a red-brown upon adding (0.288 g, 2 mmol) of quinoline-8-ol in 5 ml methanol. The solution was further refluxed for 24 hours. The solvent was then reduced by half; the precipitate was filtered and dissolved in a minimum amount of CH2Cl2. Dark crystalline solid was obtained by storing the filtrate overnight in a refrigerator. The product was filtered, washed three times with ethanol (5 mL), and left to dry at room temperature to obtain 0.6 g in 44% yield [17].
Synthesis of methoxyoxobis (quinolin-8-olato-k2N, O) vanadium (V)
[VO(C9H6NO) 2(CH3O)] was prepared according to the literature. Brown crystals were obtained in 61.4% yield (0.74 g). The crystallographic data have already been published by Guo Z et al. [18]. The melting points, elemental analyses, and spectroscopic data for the Schiff base ligand and complexes are presented in Table 1. All data indicate the formation of complexes and ligand.
Electrochemical measurements
Cyclic voltammetry was performed on 10-3 M solutions of [VO(L)(Hq)] and its vanadyl acetylacetonate precursor using a glassy carbon working electrode, Ag/Ag+ reference electrode, and a platinum wire counter electrode. The scans were done at a 100 mv/s rate in DMSO.
The supporting electrolyte was a 0.1 M solution of tetrabutylammonium bromide.
Antimicrobial assessment
The antibacterial activities of [VO(L)(Hq)] and [VO(Hq)2(CH3O)] were tested against both gram-positive and gram-negative (Staphylococcus aureus ATCC 25923, Bacillus subtilis ATCC 19659, Enterococcus faecalis (Group D Streptococcus) ATCC 11700, and Escherichia coli ATCC 25922) bacteria through execution of the established agar well diffusion methodology [19]. The bacterial suspension was diluted to 0.5 McFarland standard and spread on Mueller-Hinton agar plates. 20 ppm solution of the complexes in 4-5 % DMSO was prepared and added to the wells. The plates were incubated for 24 to 48 hours at 30 ± 5 °C. The activity was measured as the diameter (mm) of the inhibition zones. Chloramphenicol was used as a positive control antibiotic.
The antifungal was tested against the Candida albicans ATCC 10231 strain using the agar well diffusion method. The activity of the complexes was assessed by placing them in wells of Muller Hinton agar inoculated with 1 × 10 CFU/ml Candida albicans spore suspension and incubating for five days at 30 ± 5 °C.
Result and discussion
The vanadium (V) complex, [VO(L)(Hq)], was synthesized as a hexa-coordinated oxovanadium species by the reaction of arginine-salicylaldehyde Schiff base ligand and quinoline-8-ol with VO(acac)2 in methanol (Scheme 1). The dark brown pseudo-crystalline product was soluble in CH2Cl2, CH3OH, C2H5OH, and DMSO, indicating its polar and non-polar characteristics. Electron donation of the azomethine group in the Schiff base and the chelating site of quinoline-8-ol through the oxygen and nitrogen atoms enhanced the stability of the complex by increasing the coordination bond number. Elemental analysis confirmed the proposed hexa-coordinated vanadium with a 1:1 ligand: metal molar ratio, as expected.
Spectral characterization
The FT-IR spectra and most important frequencies of the vanadyl complex and Schiff base ligand are shown in Figures 1 and 2 and Table 1. According to the ligand spectrum, OH stretches from phenol and acid groups are observed at 3411 and 3370 cm-1, respectively, which are missing in the complex spectrum. The CH2 stretches appeared at 2961 and 2865 cm-1. These stretch vibrations undergoing bathochromic shifts to lower wavenumbers indicate the binding of the ligand to the metal ion. The carbonyl shift from 1592 to 1573 cm-1 indicates changes in C=O bonding due to coordination. The carboxylate peaks fit the monodentate configuration of the COO-oxygen metal. The azomethine shift from 1633 to 1604 cm-1 indicated nitrogen coordination [8]. The C=C bond of the aromatic ring was observed at 1496 cm-1 and 1468 cm-1. The new quinoline bands at 1266 and 1318 cm-1 confirm the nitrogen coordination. The V=O band was observed at 954 cm-1, and the V-O and V-N stretches at 638 cm-1 and 536 cm-1, respectively, confirming the bonding of the ligand [20]. IR spectral changes, including shifts, new peaks, and loss of stretches, are entirely consistent with the proposed coordination mode of the deprotonated tridentate Schiff base through azomethine N and carboxylate O, and bidentate quinoline via nitrogen donors. The IR data provided clear evidence of the ligand structure and binding in the complex. Figure 3 depicts the IR spectrum of [VO(Hq)2(CH3O)]. Peaks at 1605, 1496, and 1266 cm-1 correspond to quinoline functional groups C=N, C=C, and C-N, respectively. The V=O, V-O, and V-N absorption peaks were detected at 954, 638, and 536 cm-1, respectively. The peaks at 3065-2806 and 1573 cm-1 correspond to the C-H aliphatic and C-O stretching vibration bond of the CH3O group. The peak at 3419 cm-1 is attributed to the C-H aromatic stretching vibration [13]. The presence of quinoline and vanadyl peaks confirms that the compound contains vanadium coordinated to quinoline ligands, consistent with the formula [VO (Hq) 2(CH3O)].

Scheme 1: Preparation of the [VO(L)(Hq)] complex

Figure 1: IR spectrum of Schiff base ligand

Figure 2: IR spectrum of [VO (L) (Hq)]

Figure 3: IR spectrum of [VO (Hq) 2(CH3O)]
The UV-Vis spectra of the Schiff base ligand and [VO(L)(Hq)] showed the expected π→π* (212 ring transition, 257 nm C=O, and HC=N transitions) and n→π* (324 nm) transitions of the ligand functional groups (Figure 4). Upon coordination with vanadium, these bands were red-shifted to longer wavelengths (279 and 375 nm) due to the metal-ligand bonding. The new low-energy Pπ→3d band at 476 nm directly confirmed the coordination of the ligand to the metal center (LMCT) [17]. In the spectrum of [VO (Hq) 2(CH3O)], the peaks at 276,305 nm correspond to π→π* and n→π*, respectively. The peak at 387 nm arose from the charge transfer process from the quinoline ligands to the vanadium metal center.

Figure 4: The UV-Vis spectra of ligand (-.-), [VO (L) (Hq)] (-), and [VO (CH3O) (Hq)].
The 1H-NMR spectra were obtained using DMSO-d6. The Schiff base spectrum (Figure 5) shows the expected peaks of the ligand protons. NMR (500 MHz, DMSO-d6): δ ppm 1.51 (m, 2H, CH2-CH2-CH2), 1.76 (m, 1H, CH-CH2), 1.93 (m, 1H,CH-CH2), 3.81 (t, 1H,CH2-NH), 3.37 (s, 1H,COOH), 6.80-7.55 (H-Ar), 8.45 (s, 1H,CH=N), 9.45 (s, 1H,NH) [16]. In the complex [VO(L)(Hq)] spectrum (Figure 6), the singlet azomethine CH=N peak at δ=8.45 ppm indicates coordination with the metal. The N-H peak at δ=9.45 ppm confirms deprotonation upon complex formation and the aromatic hydroxyquinoline peaks from δ=7 to δ=8.69 ppm fit bidentate coordination. Arginine’s aliphatic protons peaks appeared at δ=1.51 to 3.81 ppm and remained after coordination. In the spectrum of [VO(Hq)2(CH3O)] (Figure 7), a singlet peak at δ=3.34 ppm belongs to the O-CH3 group, and the quinoline’s aliphatic protons peaks appeared at δ=7.13-8.49 ppm. The integrations matched the number of protons, further confirming the formation of the complex.
13C-NMR spectra of the Schiff base ligand and complexes recorded in DMSO-d6. Chemical shift assignments are presented in Table 1. The full spectra showing the characteristic peaks are provided in the Supplementary Data. 13C-NMR spectra of the Schiff base [16] and corresponding vanadium complex revealed characteristic azomethine carbon peaks at δ=163.1ppm and δ=162.1 ppm, respectively. It provides evidence confirming the presence of imine functionalities in both compounds. The peaks ranging between δ=25.5-52.1 ppm for the ligand and δ=24.6-60.4 ppm for the complex were attributed to the aliphatic carbon atoms of the arginine backbone. The carboxyl carbons of both compounds were observed at δ=183 ppm. Resonances between δ=117.3-132.3 ppm for the ligand and δ=116.8-162.1 ppm for the complex were assigned to the salicylaldehyde aromatic ring carbons. The distinctive HN-C=NH carbon peak for free ligand and complex appeared at δ=157.2 ppm and δ=156.9 ppm, respectively. The peaks from δ=110.9 to δ=156.9 ppm corresponding to the quinoline ligand were seen in the complex spectrum. These data corroborate the successful formation of the Schiff base and its coordination with the vanadium complex. In the [VO (Hq) 2(CH3O)] 13C-NMR spectrum, the methoxide ligand displayed a peak at approximately δ=48 ppm, while the hydroxyquinoline ligands generated signals between δ=110-163 ppm.

Figure 5: 1H-NMR spectrum of Schiff base ligand

Figure 6: 1H-NMR spectrum of [VO(L)(Hq)]

Figure 7: 1H-NMR spectrum of [VO (Hq) 2(CH3O)]
Electrochemical activity
Cyclic voltammograms of 10-3 M solution of the VO(acac)2 and [VO(L)(Hq)], were performed using DMSO, with a scan rate of 100 mV/s and the potential from -1.5 to 1.5 V (Figure 6). According to the voltammogram, VO(acac)2 exhibited two cathodic peaks at approximately -0.15 V and -1.12 V, corresponding to the stepwise reduction of vanadium (V) to vanadium (IV) and vanadium (IV) to vanadium (III), respectively. In the complex voltammogram, these peaks shift to more positive potentials of -0.06 and -0.8 V, which indicates the ligands are making vanadium harder to reduce by modifying its electronic environment. Redox activity is only observed for the vanadium complex, and the ligands do not show redox behaviour (Figure 8) [21].

Figure 8: Cyclic voltammograms of [VO(L)(Hq)] (--►--) and VO(acac)2 (--●--) at scan rates 100 mV/s
Table 1: Elemental analysis, melting points, UV-Vis, FT-IR, 1H-NMR, and 13C-NMR data of Schiff base ligand, [VO(L)(Hq)], and [VO(Hq)2(CH3O)]
|
Analysis |
[VO(L)(Hq)] |
Shiff base ligand |
[VO(Hq)2(CH3O)] |
|
|
Melting point |
190 |
203-205 |
193-195 |
|
|
Elemental analysis Found/(calculate) |
C% |
54.90/(54.22) |
57.17/(56.10) |
59.06/(58.77) |
|
N% |
14.42/(14.37) |
20.54/(20.13) |
7.55/(7.21) |
|
|
H% |
4.43/(4.55) |
6.84/(6.52) |
4.91/(4.41) |
|
|
UV-Vis λmax(nm) |
π→π* |
279 |
212, 257 |
276 |
|
n→π* |
375 |
324 |
305 |
|
|
Pπ→3d |
476 |
- |
387 |
|
|
IR( υ/cm-1) |
OH(phenol/acid) |
- |
3411/3370 |
- |
|
N-H |
3333 |
3315 |
- |
|
|
C-H |
2904-2806 |
2961-2864 |
2904-2806 (CH3) |
|
|
C=N |
1665 |
1662 |
1605 |
|
|
HC=N |
1620 |
1633 |
- |
|
|
C=O |
1573 |
1592 |
- |
|
|
C=Cring |
1496, 1468 |
1519,1478 |
1496 |
|
|
C-O |
1373 |
1343 |
1573 |
|
|
C-NAr |
1265 |
- |
1266 |
|
|
V=O |
954 |
- |
954 |
|
|
V-O |
638 |
- |
638 |
|
|
V-N |
536 |
- |
536 |
|
|
1H-NMR δ (ppm) |
2H(CH2-CH2) |
3.15 |
3.81 |
- |
|
H-Ar |
6.8-8.83 |
6.8-7.55 |
7.13-8.49 |
|
|
1H(CH=N) |
8.69 |
8.45 |
- |
|
|
1H(N-H) |
9.77 |
9.45 |
- |
|
|
1H(CH-COOH) |
- |
3.81 |
- |
|
|
H(O-CH3) |
- |
- |
3.34 |
|
|
H(N-Hamine) |
2.5 |
1.93 |
- |
|
|
13C-NMR δ (ppm) |
azomethine |
162.1 |
163.1 |
- |
|
HN-C=NH |
156.9 |
157.2 |
- |
|
|
C-Carginine |
24.6-60.4 |
25.5-52.1 |
- |
|
|
Csalicylaldehyde ring |
116.8-162 |
117.3-132.3 |
- |
|
|
Ccarboxyl |
183.5 |
183 |
- |
|
|
Cquinoline ring |
110.9-156.9 |
- |
110-163 |
|
|
C(O-CH3) |
- |
- |
48 |
|
Antimicrobial activity
The antimicrobial activities of the new [VO (L) (Hq)] were evaluated against Gram-positive and Gram-negative bacteria, Staphylococcus aureus, Enterococcus faecalis, Bacillus subtilis, and Escherichia coli, as well as the fungus Candida albicans. The inhibition zone (IZ) diameters were compared with those of the complex [VO(Hq)2(CH3O)]. All data are presented in Table 2 and Figure 9. The results demonstrated satisfactory antibacterial and antifungal properties of [VO(L)(Hq)], especially against the gram-positive bacterium Staphylococcus aureus, which was even greater than that of the antibiotic chloramphenicol. The enhanced effects of [VO(L)(Hq)] compared with [VO(Hq)2(CH3O)] can be attributed to the HC=N group in the Schiff base ligand, which likely inhibits enzyme activity in the bacterial membrane and promotes penetration through the bacterial membrane [8,22]. However, [VO (L) (Hq)] showed slightly less inhibition of Bacillus subtilis compared with the quinoline-8-ol-only complex. This is probably due to the presence of amino acid in [VO(L)(Hq)], which may provide nutritional benefits to Bacillus subtilis by serving as a carbon and nitrogen source [23]. Both complexes exhibited partial resistance against Gram-negative E.coli, likely because of the outer membrane barrier [24]. The overall effect of Schiff bases in terms of antibacterial activity versus nourishing bacteria depends on various factors, including concentration, specific Schiff base compound (side chain of amino acid), and the type of bacteria involved. Overall, the results demonstrate that coordination of the Schiff base ligand improved the antimicrobial properties of [VO(L)(Hq)] against the evaluated bacterial and fungal strains compared to those of the [VO(Hq)2(CH3O)] complex.
Table 2: Antimicrobial activity of [VO(L)(Hq)], and [VO(Hq)2(CH3O)], 20 ppm (IZ)
|
Microorganism |
S. aureus |
E. faecalis |
B. subtilis |
E. coli |
C. albicans |
|
[VO(L)(Hq)] inhibition zone (mm) |
35 |
29 |
33 |
Defective zone |
26 |
|
[VO(Hq)2(CH3O)] inhibition zone (mm) |
31 |
23 |
36 |
Defective zone |
16 |
|
Chloramphenicol inhibition zone (mm) |
32 |
|
|
33 |
|
Figure 9: Biological activities of [VO(L)(Hq)] (cod: TK61) and [VO(Hq) 2(CH3O)] (cod: TK63), a: Staphylococcus aureus. B: Enterococcus faecalis. C: Candida albicans. D: Bacillus subtilis. E: Escherichia coli. F&G: Chloramphenicol against Staphylococcus aureus and Escherichia coli
Conclusion
A new oxovanadium (V) complex, [VO(L)(Hq)], including a salicylaldehyde-arginine Schiff base and quinoline-8-ol ligand, was synthesized and structurally authenticated using 13C-NMR, 1H-NMR, IR, UV-Vis, cyclic voltammetry, and elemental analysis. The obtained results indicate an octahedral geometry around the vanadium center. Antimicrobial studies of [VO (L) (Hq)] and [VO (Hq) 2(CH3O)] against various bacteria and fungal strains demonstrated the successful use of the Schiff base ligand to improve the activity of the metal complex, which was probably due to the azomethine presence. CH=N groups have intrinsic antibacterial properties and can facilitate binding with biological macromolecules, thereby increasing the antimicrobial activities of the Schiff bases. This study provides an effective strategy for tuning biological activity through ligand design. We hope that this foundational study will pave the way for future studies.
Acknowledgments
This research is supported by Payame Noor University of Tehran, Iran based on the Ph.D. thesis of Ms.Tahmineh Kohanfekr.
Disclosure Statement
No potential conflict of interest was reported by the authors.
Funding
This study did not receive any specific grant from funding agencies in the public, commercial, or not-for-profit sectors.
Authors' contributions
All authors contributed toward data analysis, drafting, and revising the paper and agreed to responsible for all the aspects of this work.
Conflict of interest
The authors declare that they have no conflicts of interest in this article.
ORCID
Mohammad Hakimi
https://orcid.org/0000-0001-8179-1622
Tahmineh Kohanfekr
https://orcid.org/0000-0002-4146-1685
Hassan Hassani
https://orcid.org/0000-0002-0210-5194
Hasan Ali Hosseini
https://orcid.org/0000-0002-0113-2326
HOW TO CITE THIS ARTICLE
Tahmineh Kohanfekr, Mohammad Hakimi*, Hassan Hassani, Hasan Ali Hosseini. Synthesis, Characterization, and Antimicrobial Studies on a New Schiff Base Complex of Vanadium (V). Chem. Methodol., 2023, 7(10) 748-760


